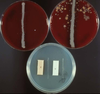

Pasteurellaceae: Haemophilus and Histophilus Flashcards
Haemophilus and Histophilus are gram ______ bacteria.
Negative
[coccobacilli]

True/False. Haemophilus and Histophilus are facultative anaerobes and opportunistic pathogens.
What does it mean to say that Haemophilus is a fastidious organism?
Needs special factors and environmental conditions to grow
Requires 5-10% CO2 for optimal growth
What is Factor X? What kind of agar would you grow these haemophiles on?
Factor X is (Hemin-protoprophyrin IX) a component in the blood
These haemophiles are grown on blood agar because it contains Factor X
What is Factor V? Which kind of agar do you grow these haemophiles on?
Factor V is NAD (nicotine adenine dinucleotide)
Use chocolate agar because it has both factors required for growth (X AND V)

How does growth of Haemophilus with Staphylococcus happen?
Staphyloccous lyses red blood cells and supplies NAD (Factor V)
Satellitism growth around Staphylococcus colonies
Which species does Haemophilus parasuis affect? What disease does it cause?
Pigs
Glasser’s disease
Key features of disease: polyserosistis, polysynovitis, meningitis

How is Haemophilus parasuis transmitted?
Spread from sows to piglets at early stage of life
How can you differientiate Haemophilus suis from Actionbacillus pleuropneumonia?
Hemolysis
CAMP +
What is the main disease caused by Histophilus somni? Which species does it affect?
Bronchopneumonoia in feedlot cattle (shipping fever)

Why was Histophilus somni removed from the Haemophilus family?
It does not need Factor X or V and can grow on blood agar
What is the main virulence factor of H. somni?
Lipooligosaccharides (LOS)
What other condition will you see with Histophilus somni and is pathognomic for H. somi infection?
Thromboemolic meningoencephalitis (TEME) - Sleeper syndrome

What are other key lesions for Histophilus somni that you won’t see with Pasteurella or Haemophilus?
Necrotic laryngitis
Myocarditis (picture)
Abortion
Vulvitis, vaginitis, cervicitis, endometritis
Orchitis

Which bacteria cause Fowl Coryza?
Avibacterium paragallinarum
[factor V dependent]
What are the clincal signs of Fowl Coryza?
Swelling of infraorbital region, oculonasal discharge, swollen wattles and diarrhea

Which bacteria resembles Pasteurella and can cause respiratory tract diseases in wild and domestic birds?
Ornithobacterium rhinotracheale
[resembles NAD-independent Actinobacillus paragallinarum]
How can you control the spread of Fowl Coryza?
Prevention
All-in/all-out farm programs with sound management and isolation methods
“biosecurity for the birds”